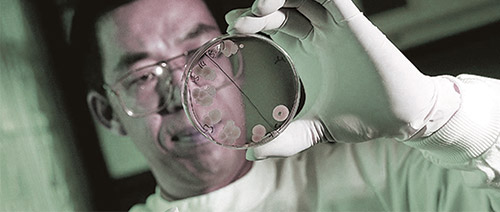

MANUFACTURE PARTNER
Established in 1994, Cultech has become internationally recognised as both an innovator and premium quality manufacturer within the nutritional supplement industry. Cultech is based in South Wales and is now a contract manufacturer for the nutraceutical, food and feed industry dedicated to constant innovation and novel research. The scientific and product development team at Cultech is led by Dr Nigel Plummer, a respected speaker on health and nutrition with a background in animal science.
GLOBAL SOURCING
Our supply chain team travel the world identifying the highest quality ingredients from the best raw material suppliers. Thanks to this attention to detail, we are able to make Protek the most effective and potent supplement possible.

OUR PROCESS
Two of the key ingredients in our product – oregano and cinnamon – have been produced through a micro-encapsulation process. These nutritional oils are converted into a completely water-miscible emulsion, which is freeze-dried under vacuum at a very low temperature without the need for solvents. This produces an oil powder where the microscopic oil droplets are locked into a starch matrix with no heat or oxidative damage through the drying cycle.
This very gentle emulsification and freeze-drying technology ensures that all the nutrients in the oils are retained and not damaged through processing. Subsequently, the oil powders are blended with the garlic and calcium to complete the final formula.





